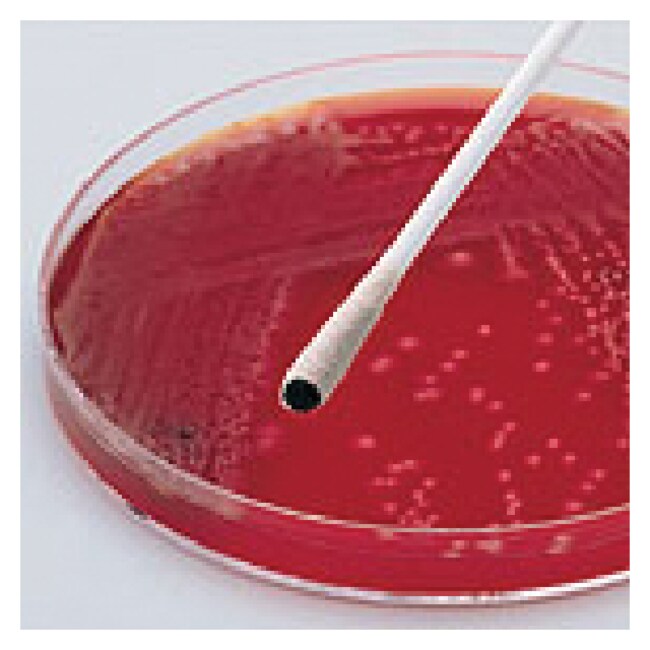

Search
Thermo Scientific™
Remel™ Oxy-Swab™
用于检测产氧化酶微生物(如奈瑟菌属和假单胞菌属)中的细胞色素氧化酶。
| 货号 | 数量 |
|---|---|
| R249348 | 4 x 25 个拭子 |
货号 R249348
价格(CNY)
-
数量:
4 x 25 个拭子
Thermo Scientific™ Remel Oxy-Swab 用于检测产氧化酶微生物(如奈瑟菌属和假单胞菌属)中的细胞色素氧化酶。
订货提示:
包装在可重新密封的铝箔袋中。25 个拭子/袋。
规格
描述Oxy-Swab™
包装类型4 袋/包
产品线Remel, Oxy-Swab
数量4 x 25 个拭子
可检测分析物产氧化酶微生物(如奈瑟菌属和假单胞菌属)中的细胞色素氧化酶
Unit SizeEach
内容与储存
2°C 至 8°C